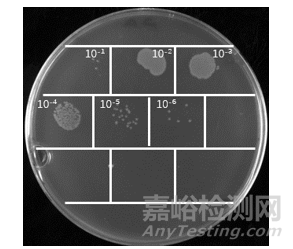
如何制備納米抗體

您當(dāng)前的位置:檢測資訊 > 科研開發(fā)
嘉峪檢測網(wǎng) 2022-03-10 12:34
納米抗體概述
抗體是由免疫B細(xì)胞受到抗原刺激產(chǎn)生的能夠特異性的和抗原結(jié)合的生物蛋白質(zhì)分子。由于其能夠高特異性,高親和的結(jié)合抗原,抗體廣泛應(yīng)用在學(xué)術(shù)研究、疾病診斷以及醫(yī)學(xué)藥物各個(gè)方面。
傳統(tǒng)抗體分子(IgG)是一種結(jié)構(gòu)相當(dāng)保守的由兩條相同的重鏈和兩條相同的輕鏈組成的蛋白分子??贵w的輕鏈包含1個(gè)可變區(qū)和1個(gè)恒定區(qū),即VL和CL。而重鏈則擁有1個(gè)可變區(qū)和3個(gè)恒定區(qū),即VH、CH1、CH2和CH3。VH區(qū)和VL區(qū)共同組成傳統(tǒng)抗體識別抗原的最小單位,抗體可變區(qū)的序列差異決定了抗體能夠特異地識別不同的抗原。而CL區(qū)和CH區(qū)則相對保守,被稱為抗體的恒定區(qū),其中CH區(qū)的CH2和CH3兩個(gè)區(qū)域?qū)τ诳贵w招募免疫細(xì)胞發(fā)揮ADCC和CDC功能有著重要的作用。
重鏈抗體為駝?lì)惡蛙浌囚~類中天然存在的僅由兩條重鏈組成的特殊抗體,包含一個(gè)重鏈可變區(qū)(VHH, Variable domain of heavy chain antibody)和兩個(gè)常規(guī)的CH2與CH3區(qū),CH1區(qū)天然缺失。重鏈抗體通過重鏈上的一個(gè)可變區(qū)(VHH)結(jié)合抗原,該可變區(qū)可以單獨(dú)穩(wěn)定地在體外存在,被稱為駝?lì)悊斡蚩贵w(SdAb)或者納米抗體(Nanobody)。納米抗體晶體直徑為2.5nm,長約4nm,分子量僅為傳統(tǒng)完整抗體的1/10(約15kD)但依然具有完整的抗原識別能力。

重鏈抗體與納米抗體示意圖
和傳統(tǒng)抗體相比,納米抗體分子量小,親水性佳,并且可以通過大腸桿菌進(jìn)行體外重組表達(dá)進(jìn)行大量生產(chǎn),有效避免傳統(tǒng)抗體的批次間差異問題。得益于以上特征,使得納米抗體在新藥物發(fā)現(xiàn)方面具有一系列優(yōu)勢,表現(xiàn)出極大的潛力:
(1)可以結(jié)合傳統(tǒng)抗體結(jié)合不到的的位點(diǎn),和靶點(diǎn)結(jié)合特異性更強(qiáng);
(2)組織穿透力更高;
(3)更高的穩(wěn)定性;
(4)適合工業(yè)化大規(guī)模生產(chǎn);
(5)更容易改造和優(yōu)化;
(6)更容易人源化
由于納米抗體的這些特征,越來越多的研究機(jī)構(gòu)和藥物生產(chǎn)企業(yè)在不同的場景中關(guān)注、嘗試使用納米抗體。而納米抗體的開發(fā)不同于傳統(tǒng)單克隆抗體通過雜交瘤制備的方法,它一般通過免疫羊駝、構(gòu)建噬菌體文庫和通過噬菌體展示來篩選出候選納米抗體,再通過納米抗體表達(dá)和純化后進(jìn)行與抗原是否結(jié)合的驗(yàn)證實(shí)驗(yàn)。下面,我們將詳細(xì)講述篩選制備納米抗體的流程以及其中的關(guān)鍵點(diǎn)和操作技巧,其中的每一個(gè)步驟均由深圳康體生命經(jīng)過多次優(yōu)化和總結(jié),供有需要和想嘗試納米抗體篩選的機(jī)構(gòu)參考。
免疫羊駝篩選單域抗體
獲得單域抗體的普遍方法是羊駝經(jīng)過抗原免疫后通過體內(nèi)免疫系統(tǒng)的作用使得抗體成熟,分離羊駝外周血B淋巴細(xì)胞,提取RNA,反轉(zhuǎn)錄獲取cDNA,以cDNA為底物PCR擴(kuò)增獲取多樣化納米抗體基因片段,然后將多樣化納米抗體基因片段連接到噬菌粒上,構(gòu)建噬菌體庫。然后通過噬菌體展示和篩選技術(shù)從羊駝抗體庫中篩選得到適合的候選納米抗體并對其進(jìn)行驗(yàn)證。整個(gè)流程主要包括羊駝免疫、噬菌體文庫構(gòu)建、抗體篩選、表達(dá)純化及驗(yàn)證等階段。

納米抗體的制備流程圖
羊駝免疫的推薦流程:
1. 抗原準(zhǔn)備:一只未免適齡羊駝可以同時(shí)免疫1-3個(gè)抗原,每次免疫每種抗原劑量保持在0.5mg左右,總體積在1.5 mL以下,免疫前將抗原和佐劑體積1:1乳化使其形成均勻混合物。
2. 羊駝免疫:記錄空白羊駝耳號后開始免疫實(shí)驗(yàn)。每次在羊駝?lì)i部淋巴結(jié)附近分左右兩側(cè)皮下注射,每側(cè)分2點(diǎn)注射,每點(diǎn)注射約0.4mL乳化好的抗原。免疫后觀察半小時(shí)確認(rèn)羊駝狀態(tài)良好,無不適癥狀。每2周免疫一次,至少進(jìn)行4次免疫。
3. 血清分離:每次抗原免疫前進(jìn)行采血用于免疫評價(jià),每次取5 mL血液;血液當(dāng)天使用預(yù)冷25℃離心機(jī),4000 rpm離心10分鐘,分離凍存上層血清,用于后續(xù)抗體效價(jià)檢測。
4. 采血:在第4次免疫后間隔5-7天從羊駝?lì)i部靜脈進(jìn)行采血50mL。
5. 分離淋巴細(xì)胞:在50mL的離心管中先加入15mL細(xì)胞分離液,然后緩慢加入15 mL血液。加入血液時(shí)小心緩慢以防止血液和分離液混勻。之后離心機(jī)預(yù)冷至25℃,400xg離心30分鐘后,觀察離心管中血液分離情況,上層血清保存在新的離心管中,-80℃保存,用移液器小心吸取出中間棉狀上層免疫細(xì)胞至新的50mL離心管中。每管加入室溫放置的10mL PBS緩沖液,25℃,400xg離心20分鐘。去除上清液,每管加入室溫放置的5mL PBS緩沖液,輕輕混勻后,使用血球計(jì)數(shù)板計(jì)算細(xì)胞數(shù)目,然后25℃,400xg離心20分鐘。去除上清液,根據(jù)細(xì)胞數(shù)目使用RNAiso Plus溶解分離得到的淋巴細(xì)胞得到107/mL細(xì)胞溶解液,-80℃保存。
免疫技巧:
1. 羊駝的選擇和選擇合適的抗原是免疫成功的關(guān)鍵。選擇健康強(qiáng)壯、精神狀態(tài)良好、體型適中的未免羊駝即空白羊駝。免疫抗原的純度以及其正確構(gòu)象對免疫羊駝后篩選到合適的抗體以及后續(xù)應(yīng)用至關(guān)重要,蛋白抗原純度一般至少不低于90%。
2. 淋巴細(xì)胞的分離:及時(shí)的細(xì)胞分離可以有效阻止血液采集后的溶血以達(dá)到最好的分離效果。
3. 免疫周期的選擇可影響免疫效果,根據(jù)經(jīng)驗(yàn),1-2周免疫間隔可以使羊駝對大部分抗原有良好的免疫反應(yīng)。

羊駝免疫及采血圖

免疫效果檢測圖
構(gòu)建噬菌體文庫
1. RNA提取:將用Trizol保存的外周血淋巴細(xì)胞冰上溶解后轉(zhuǎn)移至1.5mL的離心管,加入1/5體積的氯仿震蕩混勻;室溫靜置5分鐘后4℃,12000g離心15分鐘;將離心后的上清液轉(zhuǎn)移到新的離心管;往新離心管中加入等體積的異丙醇;顛倒混勻室溫靜置10分鐘后4℃ 12000g離心10分鐘;棄上清后用75%乙醇清洗沉淀,4℃ 7500g 離心5分鐘后棄去上清,沉淀室溫晾干后溶解于適量的無RNA酶的水中。
2. 反轉(zhuǎn)錄獲取cDNA:按照反轉(zhuǎn)錄試劑盒說明書將上一步得到的RNA一分為二反轉(zhuǎn)錄成cDNA,反轉(zhuǎn)錄引物分別用Oligo dT及random primers。
3. 抗體片段擴(kuò)增:從反轉(zhuǎn)錄的cDNA中擴(kuò)增特定的抗體片段,使用Taq DNA Polymerase Hot Start酶進(jìn)行PCR擴(kuò)增。PCR反應(yīng)體系為:cDNA模板 2µL,Alpa001F引物2 µL,Alpa001R引物 2µL,10x Taq Buffer 5µL,dNTP 4µL, Taq(HS) 0.25µL,ddH2O補(bǔ)足到50µL。PCR的反應(yīng)條件為:98℃ 3分鐘;95℃ 30秒,57℃30秒,72℃ 40秒,每個(gè)循環(huán)增加2秒,重復(fù)22個(gè)循環(huán);72℃ 5分鐘。將得到的PCR擴(kuò)增產(chǎn)物進(jìn)行1%瓊脂糖凝膠電泳,可以看到一條1.0kb 左右一條0.7kb 左右的PCR條帶,對0.7 kb大小的條帶切膠使用DNA純化回收試劑盒按說明書進(jìn)行回收。以上一步PCR擴(kuò)增并回收后的DNA片段作為模板再次擴(kuò)增特定的抗體片段,使用Taq DNA Polymerase Hot Start Version酶進(jìn)行PCR擴(kuò)增。PCR反應(yīng)體系為:DNA模板 2ul,Alpa002F引物 2µL,Alpa002R引物 2µL,10x Taq Buffer 5µL, dNTP 4µL, Taq(HS) 0.25µL, ddH2O補(bǔ)足到50µL。PCR的反應(yīng)條件為:98℃ 3分鐘;95℃ 50秒,55℃30秒,72℃ 40秒,重復(fù)12個(gè)循環(huán);72℃10分鐘。將得到的PCR擴(kuò)增產(chǎn)物使用DNA純化回收試劑盒按說明書回收。
4. 克隆至噬菌體質(zhì)粒:將上一步擴(kuò)增得到的多樣化抗體基因序列和噬菌體載體進(jìn)行酶切,各自純化并進(jìn)行鏈接反應(yīng)。將連接產(chǎn)物使用DNA純化回收試劑盒按說明書回收,并使用超純水溶解。
5. 轉(zhuǎn)化TG1:提前將無菌的電轉(zhuǎn)杯置于冰上預(yù)冷,待TG1感受態(tài)細(xì)胞50µL融化后加入100ng回收后的連接產(chǎn)物,將混合后的感受態(tài)細(xì)胞和連接產(chǎn)物轉(zhuǎn)移到預(yù)冷好的電轉(zhuǎn)杯中,使用電轉(zhuǎn)儀預(yù)設(shè)的Bacteria轉(zhuǎn)化程序電擊轉(zhuǎn)化,電轉(zhuǎn)后立即往電轉(zhuǎn)杯中加入1mL SOC培養(yǎng)基,至少進(jìn)行20個(gè)電轉(zhuǎn),將細(xì)胞37℃復(fù)蘇60分鐘后涂在含有氨芐抗性的LB培養(yǎng)板上過夜生長。將上一步過夜生長后的培養(yǎng)板上的細(xì)胞用2xYT培養(yǎng)基和涂布棒沖洗刮下,加入20%的甘油測OD600nm值后保存在-80℃,即為菌庫。
6. 擴(kuò)增和純化噬菌體文庫:將上一步刮下的菌體混勻后將數(shù)目約為10^9個(gè)細(xì)菌轉(zhuǎn)移到100 mL預(yù)先加入氨芐抗生素的2xYT培養(yǎng)液中,37℃ 220rpm培養(yǎng)直至OD600nm達(dá)到0.5。按照輔助噬菌體:細(xì)菌細(xì)胞數(shù)目為20:1的比例加入輔助噬菌體后繼續(xù)37℃培養(yǎng)30分鐘。加入終濃度為50µg/mL的卡那霉素,30℃過夜搖床培養(yǎng)。將過夜培養(yǎng)的細(xì)菌4℃ 13000 rpm離心5分鐘,將上清轉(zhuǎn)移到新的離心管后加入1/4體積預(yù)冷的 5x PEG8000/NaCl,在冰上孵育30-60分鐘。4℃ 13000 rpm離心10分鐘去除上清后加入1 mL PBS緩沖液溶解沉淀。再次加入250µL 5X PEG8000/NaCl 后冰上孵育10分鐘,4℃ 16000xg離心15分鐘后去除上清并將沉淀溶解在1mL PBS中得到噬菌體庫,長期-80℃保存,短期(1-2周)可于-20℃放置保存。
構(gòu)建噬菌體庫技巧:
1. 噬菌體文庫的庫容量和多樣性是衡量文庫質(zhì)量的重要標(biāo)準(zhǔn)之一,容量越大、多樣性越好的庫是成功篩選出納米抗體的有效保證;
2. 影響文庫容量和多樣性的關(guān)鍵點(diǎn)包括:提取RNA過程中RNA的降解、反轉(zhuǎn)錄過程中的模板和引物、擴(kuò)增過程中引物的選擇和模板的用量以及PCR擴(kuò)增輪數(shù)、感受態(tài)細(xì)菌的轉(zhuǎn)化效率、連接體系的大小等因素。


第一輪PCR
抗體篩選鑒定
抗體篩選鑒定推薦流程:
1. 包被免疫管:將50µg 抗原加入到2mL PBS中并加入到免疫管中,4℃緩慢旋轉(zhuǎn)過夜孵育。
2. 封閉:將適量擴(kuò)增和純化的噬菌體 加入到1mL 3% BSA中,室溫旋轉(zhuǎn)孵育2小時(shí)。同時(shí)往包被好的免疫管中加入2-3mL 3% BSA,室溫旋轉(zhuǎn)孵育2小時(shí)。
3. 抗原和噬菌體孵育:將封閉后的免疫管用含有0.01%吐溫的PBS洗3次,每次5分鐘。將封閉后的噬菌體文庫加入到封閉后的免疫管中,添加PBS直至2-3 mL,室溫旋轉(zhuǎn)孵育1小時(shí)。
4. 清洗:將抗原和噬菌體孵育后的免疫管用含有0.1%吐溫的PBS洗20次,每次5分鐘。
5. 洗脫:將免疫管內(nèi)液體棄掉,盡量去除殘余液體,加入1mL 0.25 mg/mL Trypsin溶液,室溫旋轉(zhuǎn)洗脫30分鐘,加入10µL 10%AEBSF終止洗脫,將免疫管中的溶液轉(zhuǎn)移至新的1.5mL離心管中,即為第一輪篩選噬菌體洗脫液。
6. 噬菌體洗脫液效價(jià)檢測:取第一輪噬菌體洗脫液10µL,在1.5mL離心管中10倍梯度稀釋,共稀釋10個(gè)梯度,在每個(gè)稀釋離心管中加入90µL OD600為0.5-0.55的TG1菌液,混勻后37℃孵育30分鐘,將各個(gè)梯度的菌液涂布到2×YT固體培養(yǎng)基(Amp)中,37℃倒置過夜培養(yǎng),第二天統(tǒng)計(jì)培養(yǎng)板上的單菌落個(gè)數(shù)并計(jì)算噬菌體洗脫液效價(jià);
7. 第一輪噬菌體洗脫液的擴(kuò)增:取500µl第一輪篩選后得到的噬菌體洗脫液至5mL OD600為0.5-0.55的菌液中,37℃,250 rpm繼續(xù)培養(yǎng)30分鐘,將全部菌液均勻涂布到含有100µg/mL Amp和2%葡萄糖的2%瓊脂糖的固體培養(yǎng)板中,37℃過夜培養(yǎng)。第二天將培養(yǎng)板的菌落刮下來收集至離心管中,即為擴(kuò)增后的細(xì)菌子文庫。按照噬菌體文庫擴(kuò)增和純化方法,再重復(fù)篩選過程2次,逐次減半包被免疫管的抗原量,得到3次篩選后的洗脫噬菌體。洗脫的噬菌體可進(jìn)行NGS測序,得到與抗原結(jié)合的候選納米抗體DNA序列庫。
8. ELISA鑒定:
將最后一輪篩選得到的噬菌體梯度稀釋后,各取10µL加入到OD600nm為0.5的TG1菌液中,37℃培養(yǎng)30分鐘后涂布含有氨芐霉素的2x YT培養(yǎng)板上,37℃過夜培養(yǎng)第二天得到單克隆菌落;
隨機(jī)挑選至少192個(gè)單菌落到含有氨芐霉素的2xYT培養(yǎng)液的96孔細(xì)胞培養(yǎng)板上,37℃過夜培養(yǎng)后作為種子菌板,重新取菌液2µL 加入新的96孔板(每孔含200µL 2x YT新鮮培養(yǎng)液,100µg/mL 氨芐),37℃培養(yǎng)5小時(shí)后,往培養(yǎng)孔中加入輔助噬菌體(每孔加入輔助噬菌體M13K07以使細(xì)菌個(gè)數(shù):噬菌體數(shù)=1:20),37℃靜置30分鐘后加入終濃度為50µg/mL的卡納霉素,30℃過夜培養(yǎng)。第二天將過夜培養(yǎng)后的菌液離心,獲得含噬菌體的上清液,4℃保存?zhèn)溆茫?/span>
將篩選抗原包被酶標(biāo)板(1ng/µL,包被液為pH9.4的CBS,100µL/孔),同時(shí)平行包被BSA作對照,4°C包被過夜;將過夜包被的酶標(biāo)板內(nèi)液體棄掉,每孔加入200µL PBS緩沖液,室溫清洗酶標(biāo)板3次,每次10分鐘;每孔加入200µL封閉液(3% BSA)封閉酶標(biāo)板,室溫封閉1小時(shí);
棄封閉液,每孔加入200µL PBST(1×PBS加0.1% Tween20,下同)緩沖液,室溫清洗酶標(biāo)板3次,每次10分鐘;
每孔加入120µL 3% BSA后再加入80 µL步驟8.2離心后得到的噬菌體上清液,室溫孵育2小時(shí);棄掉酶標(biāo)板內(nèi)液體,每孔加入200µL PBST緩沖液洗滌3次,每次10分鐘;
每孔加入M13 Bacteriophage Antibody(HRP),Mouse Mab,0.1ng/µL稀釋于封閉液中,100µL/孔,室溫孵育1小時(shí);
棄掉ELISA板內(nèi)液體,每孔加入200µl PBST緩沖液洗滌3次,每次10分鐘;
每孔加入100µL TMB單組份顯色液,避光顯色2-3 分鐘,每孔加入100µL 1M Hcl終止,用酶標(biāo)儀讀取OD450值,記錄并保存;
選取抗原包被孔與相應(yīng)對照孔吸光值比例大的菌落送去測序(獨(dú)立兩次phage-Elisa分析),得到候選納米抗體的基因序列。
抗體篩選技巧:
1. 合適量的抗原包被和抗原的分子量大小、疏水親水性質(zhì)、結(jié)構(gòu)有關(guān),也和包被緩沖液和包被介質(zhì)的選擇有關(guān),合理的包被是成功篩選的基礎(chǔ),如果有必要可以進(jìn)行預(yù)實(shí)驗(yàn)確定包被的條件或者可選擇抗原結(jié)合磁珠的方法進(jìn)行篩選。
2. 洗脫后測定噬菌體的效價(jià),經(jīng)過2-4輪抗原包被淘選后,噬菌體的富集程度需要在合理范圍之內(nèi)。
噬菌體洗脫液效價(jià)檢測

Phage Elisa
納米抗體表達(dá)純化
Phage-Elisa篩選出的單克隆菌株進(jìn)行納米抗體片段DNA測序后即可進(jìn)行表達(dá)純化及驗(yàn)證。
納米抗體可在大腸桿菌,酵母或哺乳動物細(xì)胞系里進(jìn)行表達(dá),因其僅含100多個(gè)氨基酸殘基,為驗(yàn)證其是否與抗原結(jié)合,可構(gòu)建質(zhì)粒在大腸桿菌中或酵母菌株中進(jìn)行快速表達(dá)及純化,或者同時(shí)在兩種菌株中進(jìn)行表達(dá)純化。
大腸桿菌中納米抗體的誘導(dǎo)表達(dá)及純化:
質(zhì)粒構(gòu)建序列確認(rèn)后轉(zhuǎn)化表達(dá)菌株,如BL21,挑取單菌落進(jìn)行搖瓶培養(yǎng)后IPTG誘導(dǎo)表達(dá),菌體破碎后將上清液中可溶蛋白進(jìn)行純化,包括親和層析,離子交換層析及分子篩層析等方法。
畢赤酵母中納米抗體的表達(dá)及純化:
質(zhì)粒構(gòu)建序列確認(rèn)后及酶切線性化后將線性化質(zhì)粒電轉(zhuǎn)進(jìn)酵母如GS115或X33菌株中,平板上篩選確認(rèn)單菌落后甲醇誘導(dǎo)表達(dá),分泌至胞外,發(fā)酵液上清中的納米抗體可直接Elisa驗(yàn)證,陽性序列進(jìn)行純化。
大腸桿菌表達(dá)的優(yōu)點(diǎn)是可迅速誘導(dǎo)表達(dá),缺點(diǎn)是部分納米抗體可形成包涵體,其胞內(nèi)還原環(huán)境不利于納米抗體中二硫鍵的形成,畢赤酵母表達(dá)的優(yōu)點(diǎn)是可利用畢赤酵母對蛋白進(jìn)行胞外分泌,從而不用進(jìn)行菌體破碎,而直接從酵母發(fā)酵上清液中進(jìn)行納米抗體純化,并且酵母很少分泌雜蛋白至胞外使得發(fā)酵上清液中的納米抗體純度相對較高從而易于純化,并且胞外的氧化環(huán)境有利于納米抗體二硫鍵的形成,納米抗體中二硫鍵的形成對納米抗體的穩(wěn)定性至關(guān)重要。
候選納米抗體純化后可驗(yàn)證其與抗原是否結(jié)合及與抗原結(jié)合的親和力檢測:
SPR實(shí)驗(yàn)利用的機(jī)型為BiacoreT200,具體操作流程詳見《BiacoreT200檢測蛋白與蛋白結(jié)合操作指南》。
納米抗體的規(guī)模表達(dá)純化:
因納米抗體為分子量約15KD左右的單鏈蛋白,其可由大腸桿菌或酵母中進(jìn)行誘導(dǎo)表達(dá)并在發(fā)酵罐中規(guī)模表達(dá),其產(chǎn)量均在g/L以上,故可進(jìn)行量產(chǎn)應(yīng)用于試劑盒檢測,甚至臨床藥物規(guī)?;慨a(chǎn)。

來源:小藥說藥、康體生命